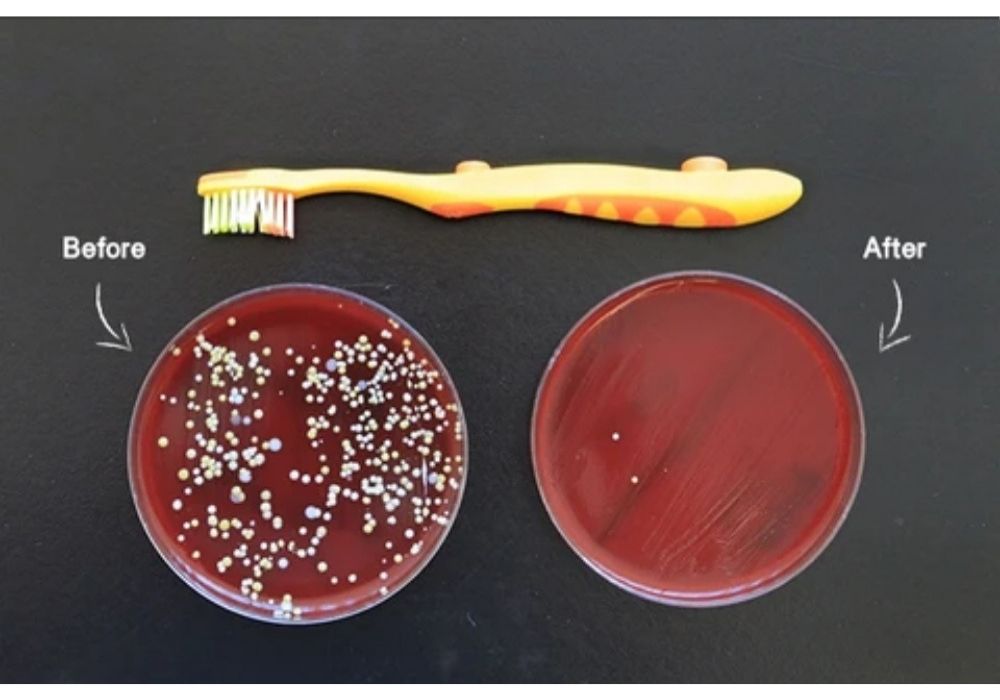

Views: 0
Perfect Cleanliness for Your Toothbrush
3-in-1 device
✅ Toothbrush holder
✅ Antibacterial sterilizer
✅ Toothpaste squeezer
This innovative UV sterilizer kills up to 99% of bacteria located on your toothbrush. That means a fresh and clean toothbrush every time you use it.
✅ Professional UV lamp to effectively sterilize and kill germs.
✅ Sterilization rate 99%.
✅ Produces ozon to achieve a bactericidal effect.
It takes only 4 minutes to disinfect.
After disinfection is completed, a built-in smart chip will ensure the UV feature powers off to prevent electricity overuse.
This Toothbrush Holder With UV Sterilizer is designed to hold 5 toothbrushes at once.
A built-in vacuum pump also helps to automatically dispense a proper amount of toothpaste.
This helps reduce waste of toothpaste and accidental spills.
The holder conveniently opens by pressing a button.
The UV sterilizer automatically switches off after 4 minutes.
Specifications:
Material: ABS, UV lamp, electronic elements
Adapter Input: 100-240V 50/60Hz; Output: 9V 509mA
Plug Type: US Plug
UV Light Power: 7W
Color: White + Gray
Weight: 12.7oz / 360g
Toothbrush Holder Size: 9 x 2.2 x 2.6in / 23 x 5.6 x 6.5cm
Toothpaste Dispenser Size: 5.1 x 2.2in / 13 x 5.6cm
Package Includes:
1 x Toothbrush Sterilizer + Toothpaste Dispenser
1 x Adapter
1 x Adhesive Pad
I really like this so far. Do I think I needed it- no. But it brings me peace of mind to know my tooth brush is clean. I does what it says it is going to do. The plug thing confuses me because it can run without being plugged In. With that said the reason for four stars is because that light for the timer is sooo bright. I like total darkness when I'm sleeping and it beams from under my closed bathroom door. Other than that it’s holding up well on the wall(I’ve had it for about a month.) will update if it falls off.
Thank you very much! Fully complies with the description. Came without a box, but in a powerful package. Everything works. As in reviews-after the work of the ultraviolet there is a characteristic smell. Plastic to the touch pleasant. Perfect holder for 5 brushes and pulling paste. It's true, it's necessary to set up the tube. Very nice looks in the bathroom. Wire with European plug-short-90 cm. I definitely recommend the store and the goods
Easy to put up. Fits 4 tootbrushes. Small, compact, doesn't take up much space. Wall plug in but did not come with power block, just usb cord. UV light is excellent for killing germs, mold, and bacteria. I love that it holds toothbrushes while not in use and has a cover. My kids loved watching the light and countdown as it sanitized great product!
This was a nice upgrade to my bathroom. I love the clean look and simplicity of use. I've only had it installed for a few days, but I followed the manufacturers clear instructions and attached only the mount for 24 hrs before putting the machine on. It seems like it's holding well. They send an extra adhesive strip in case, but you can always get some heavy duty 3M branded tape for extra stickiness. My only concern is that I can still see the blue light when the cover is closed. I'm afraid of uv exposure, so I just make sure everyone leaves the bathroom while it's disinfecting.
I’ve always wanted a toothbrush sanitizer but this pandemic time made me get one faster as I look for ways to make my home cleaner. This product is well made and sturdy and easy to set up and begin using out of the box. It cleans 4 Brushes at a time and automatically starts cleaning just by closing the cover after you place your toothbrush inside! I love the feeling of security that my toothbrush is clean and sanitized. Great product and strong construction.
This toothbrush holder is simply beautiful! Very happy with buying! We actually used screws to attach it to the wall. I really like the functionality of this UV toothbrush holder. Glad I ordered it.
Super! So quickly delivered, Toothbrush Holder was packed well!!!))) Thank you so much!!!!
superrr.i love the product. the light works great. didn t put it on the wall but i will. looks like a quality Toothbrush Holder. i will put toothpaste to see witch fits...
It is a magnificent device because it helps me keep the whole family's toothbrushes tidy and clean. It is very easy to install on the bathroom wall, it should only be plugged in to start working and disinfect and sterilize up to 4 toothbrushes at the same time using an ultraviolet light
Product seems to work well. I would love to test the reduction of bacterial matter from having toothbrushes exposed on bathroom counter to using the UV sterilizer, but it definitely feels fresh.
It's a rather simple product. It holds your toothbrush. Detects when lids closed, and you manually press the button to disinfect. Battery seems to last about 2 weeks or so. It could use a bigger battery, but for those with a close by plug, this isn't really an issue. Only other thing that would be nice is a sensor to detect when you leave the room so that it can start disinfecting.
I bought this mostly for display purposes, cause toothbrush were just lying willy nilly on the bathroom vanity, so the fact that it also sanitizes is just a bonus. it has an easy install with double sided tape, though I contemplated putting it in the shower with some silicone, because we do brush our teeth in the shower sometimes as well. havent given that a shot yet, but will update if I do.
this product is good. One day I thought it was done (broken) wasn't sterilizing and I was bummed but my 3 yr old decided to tell me she was washing it so it probably had water in it .so couple days later I tried charging it again and it starts to work again I'm very sorry if my last review discourage buyers not to buy but the product Does work and it "broke" because of my child
Saves alot of counter space Also saves alot of toothpaste. I love it
Holder arrived within 2 weeks in perfect condition. Great store. Highly recommend!
Gave em to our adult kids for Christmas and they love it! Easy install, works great, no mess!
Don't know about sanitizing, but the brushes do seem cleaner with this holder. So guess it works.
I like it very much. After installing it I feel my teeth are safer :-)
I love this toothbrush sterilizing kit it looks great and does the job
Very smart, my father likes it very much. My father has always favored electronic products. This bathroom product can also put his razor, NICE.
nicely made and gives the bathroom a bit of futuristic look
was pleasantly surprised with the design
The goods came very well packed, the ultraviolet works.
Very nice toothbrush holder and Sanitation. I was told about how bad it is to have your toothbrushes out in the open in the bathroom so I decided to try this, and so far it is awesome! Very easy to use and install.
This is what I have been looking for, charge the battery and put it back on the wall, no cords, very convenient. My family loves it!
The goods received, packed very well, this product must have a smooth surface to adhere to; unfortunately my bathroom has no such place except the mirror. it can also be screwed into the wall but I am not comfortable with that. I am using the product by laying if flat on the counter top. It works well, but I kinda disappointed with the mounting options.
Used it as a holder - sterilizer for some time, and just recently decided to incert a toothpaste. works great!
This is the best cleaner ever. I use this 2x a day every day for the past 11 days. I used a blue light that detects dirt and grime after and it came clean. This will literally save your toothbrushes and keep them healthy until time to change. Great price. Only takes a few mins and your toothbrushes are clean as a whistle
Everything works. only has not yet figured out how to paste and how to use
Lamp lights feel peculiar smell for this type of lamp, so probably works :)
Installation is simple. Works great! It comes with everything you need to adhere to or mount to a surface available to you. Easy to remove for recharging.
This is first time I have it. Look like very good. Before I always leave my teeth brushed on cup, and and it was dirty after few days. Now I hold my teeth brush on the wall and can kill the gem. I use for a week it looks good.
Best toothbrush sanitizer yet. Sleek, so easy to use. Just wish the charging cord was longer because my outlet is on the opposite side of the room
Ive wanted one of these for awhile. Pretty simple functions. It definitely freed up some space in my medicine cabinet. Satisfied with my purchase.
Everything is well packed. I was worried it would break in the delivery, but all came intact and working.
So far so good its a nice place to store the tooth brushes when not in use
Very cool antibacterial holder. Beautiful design! Holds everyones toothbrush and sanitizes them effortlessly. Great product to save counter space & have a clean toothbrush. Very great product!
Get little device works great is good knowing all the tooth brushes and clean of grems 😁
I love the fact that my toothbrush is not exposed to toilet germs. When u finish brushing just put ur brush in it and press the sanitize button. It sanitizes for 6 min. then turns off until the next time.
Great product, it works perfectly. Toothbrush Holder just as described.
Very fast delivery! It works. It smells nice of ozone in the work of the ultraviolet. Recommend store and goods!